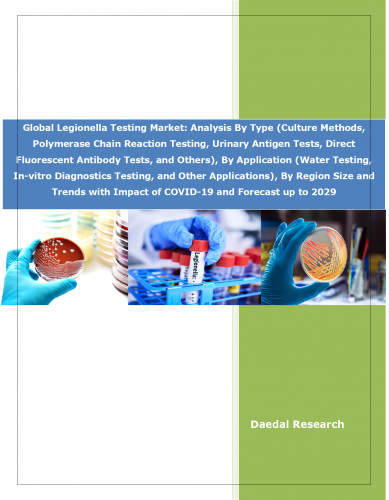

Global Legionella Testing Market: Analysis By Type (Culture Methods, Polymerase Chain Reaction Testing, Urinary Antigen Tests, Direct Fluorescent Antibody Tests, and Others), By Application (Water Testing, In-vitro Diagnostics Testing, and Other Applications), By Region Size and Trends with Impact of COVID-19 and Forecast up to 2029
Legionella is a bacteria that cause legionellosis, a type of pneumonia. Legionella testing is essential for assessing the risk of Legionnaires' disease outbreaks & implementing appropriate control measures to prevent transmission of disease to vulnerable groups. The legionella testing market refers to the market for products and services such as diagnostic tests, kits, reagents, instruments, etc., that are used to detect and prevent Legionella bacteria contamination in water systems. Environmental evaluations, risk management advice, and remediation services are some of the services provided by the Legionella testing sector in addition to standard water testing. The global legionella testing market value stood at US$315.08 million in 2023, and is expected to reach US$514.90 million by 2029.
Global legionella testing market demonstrated a consistent growth, primarily driven by growing cases of pneumonia, increasing incidences of infectious diseases, rapidly aging population, rising demand for point-of-care testing, increasing awareness about the importance of infection prevention & control after COVID-19 pandemic, rapidly expanding healthcare infrastructure in developing economies, etc. According to WHO, in Europe, Australia and the US, there are about 10–15 legionella cases detected per million population per year. Globally increased awareness of Legionnaires' disease, presence of strong laws promoting public water safety, growing focus of healthcare facilities on patient safety, & ongoing advancements in immunodiagnostic technologies and automation are some of the prime growth factors that will continue to drive the growth of global legionella testing market. The market is expected to grow at a CAGR of 8.53% over the projected period of 2024-2029.
Market Segmentation Analysis:
By Type: The report provides the bifurcation of the global legionella testing market into five segments on the basis of type: culture methods, polymerase chain reaction testing, urinary antigen tests, direct fluorescent antibody tests, and others. The culture methods is the largest segment of global legionella testing market owing to their high specificity and sensitivity, rise in culture methods integration with newer technologies such as rapid identification testing, increasing public awareness about Legionnaires' disease, and regulatory guidelines and standards recommending the use of culture methods for Legionella testing in certain settings, such as healthcare facilities and cooling towers. The polymerase chain reaction testing is the fastest growing segment of legionella testing market owing to its quick turnaround time and precision in detecting low concentrations, growing preference for increasingly user-friendly PCR testing kits with simplified protocols and ready-to-use reagents, rising demand for rapid molecular diagnostics, and growing focus of government on public health surveillance.
By Application: The global legionella testing market, on the basis of application, can be divided into three segments, namely, water testing, in-vitro diagnostics testing, and other applications. The water testing segment is the largest and fastest growing segment of legionella testing market, driven by mandatory regulations in many countries for testing water sources in buildings with complex water systems, rising number of regulatory bodies and public health agencies mandating stringent testing and monitoring protocols, increasing demand for water testing services across industries, healthcare facilities, and public places, growing need for legionella testing in water treatment plants for ensuring safety and purity of water supplies, increased need for regular monitoring of water systems to prevent potential outbreak, and growing public emphasis on legionella risk management.
By Region: The report provides insight into the legionella testing market based on regions namely, Europe, North America, Asia Pacific, and rest of the world. North America is the largest region of global legionella testing market as a result of high diagnosis rates for Legionnaire's disease, strict water examination requirements, North America's aging population, presence of well developed healthcare systems, heightened focus on preventive measures and regular testing, and increased presence of regulatory framework that emphasizes the importance of legionella testing for public health and safety. Also, to manage the prevalence of legionnaires diseases, the Government of the US is increasing awareness among the general public with the environmental legionella isolation techniques Evaluation (ELITE) program, which may further augment the growth of the market.
Asia pacific is the fastest growing region of legionella testing market owing to rapid population growth, empowered healthcare industry, increasing awareness about available test products in the region, rapid urbanization & infrastructure development in China and India, increasing focus of government on expanding Legionella testing services, rising awareness about Legionnaires' disease, and ongoing advancements in healthcare infrastructure and diagnostics capabilities. Countries like China, Japan, and Australia are likely to have active markets for Legionella testing, especially in high-density urban areas and healthcare and hospitality industries.
Market Dynamics:
Growth Drivers: The global legionella testing market has been rapidly growing over the past few years, due to factors such as aging population, increasing legionella testing demand from hospitality sector, rising incidence of pneumonia and legionella-related illnesses, increasing focus of government on public health, aging infrastructure, etc. As buildings and their plumbing systems age, corrosion can lead to the buildup of scale and sediment, providing ideal breeding grounds for legionella. Rising demand for legionella testing in public buildings, fountains, care facilities, hospitals, and cooling towers, and increased need for regular monitoring and testing of water systems in commercial buildings, hotels, & other high-risk environments creates a continuous demand for legionella testing services and products. Furthermore, an increase in Legionella-related illnesses has led to a greater emphasis on preventive measures, with regulatory bodies imposing stricter guidelines & regulations for legionella testing and water management including regular testing & monitoring of water systems. Therefore, facilities are proactively implementing these measures to prevent outbreaks, driving the demand for Legionella testing.
Challenges: However, the global legionella testing market growth would be negatively impacted by various challenges such as increased difficulty in legionella detection, limited awareness about the disease in underdeveloped countries, etc. Interpreting legionella test results accurately and taking appropriate actions based on these results is a complex process, resulting in misinterpretation, an improper response, or unnecessary remediation efforts. Due to the complexity of these processes, smaller companies or facilities with fewer resources may find it difficult to implement thorough Legionella testing programs, which could impede the expansion of the industry as a whole.
Trends: The global legionella testing market is projected to grow at a fast pace during the forecasted period, due to increasing adoption of water conservation practices, growing focus on adopting preventive measures, ongoing advancements in diagnostic technologies, integration of IoT, rising demand for rapid diagnostic tests, etc. Increasing number of industries, commercial buildings, and healthcare facilities are prioritizing legionella testing as part of their risk management and safety protocols, creating positive demand for preventive services, including regular testing, maintenance, and consultation, in water system safety. So, with increasing number of industries, establishing standards and best practices for legionella testing as part of their preventive measures, there is a growing focus of industries on adopting these standards, boosting the demand for legionella testing services and products. Also, water conservation practices often involve the use of complex water systems, such as rainwater harvesting systems, greywater recycling systems, and low-flow fixtures, providing additional reservoirs for Legionella bacteria to grow and increase the complexity of monitoring and managing water quality. As a result, there is a greater need for legionella testing to ensure the safety of these systems.
Impact Analysis of COVID-19 and Way Forward:
COVID-19 brought in many changes in the world in terms of reduced productivity, loss of life, business closures, closing down of factories and organizations, and shift to an online mode of work. Healthcare facilities, such as hospitals & nursing homes were hyper-focused on preventing the spread of infections throughout the pandemic. Under immense pressure during COVID-19, hospitals prioritized legionella testing to minimize the risk of hospital-acquired Legionnaires' disease adding to COVID-19 cases. So the overall impact of COVID-19 on legionella testing market tuned out to be positive, with increasing number of hospitals putting greater emphasis on water testing and hence experiencing a surge in demand for legionella testing services & devices.
Competitive Landscape:
The global legionella testing market is relatively fragmented with increasing number of large and medium sized players accounting for the majority of market revenue. The key players of the global legionella testing market are:
F. Hoffmann-La Roche Ltd
Abbott Laboratories
Merck KGaA
Bio-Rad Laboratories, Inc.
Becton, Dickinson and Company
QuidelOrtho Corporation
Thermo Fisher Scientific Inc.
IDEXX Laboratories, Inc.
Qiagen
Takara Bio Inc.
Eiken Chemical Co., Ltd.
AquaCert Ltd
Pro Lab Diagnostics Inc.
Major players in the market are engaged in expanding their product portfolio to accommodate advanced testing methods such as UAT and PCR, and implement strategic initiatives, such as a merger, new product launches, acquisitions, etc., to help them strengthen their market position. For instance, on December 07, 2021, Pace Analytical Services, announced that the company has acquired Special Pathogens Laboratory, a Legionella testing, detection, remediation, and prevention company. Startups prioritizing agility, innovation, and customer-centricity are also changing market & raising competition, certainly leading to better risk management techniques and public health results. Also, innovative entrepreneurs have used technological breakthroughs to challenge existing players of traditional testing methods in the highly competitive market sector inside the startup ecosystem. Increasing number of startups are introducing new testing solutions, like IoT-enabled monitoring devices, AI-powered analytics platforms, and quick testing kits.
Tags :
1. Executive Summary
2. Introduction
2.1 Legionella Testing: An Overview
2.1.1 Definition of Legionella Testing
2.1.2 Benefits of Legionella Testing
2.2 Legionella Testing Market Segmentation: An Overview
2.2.1 Legionella Testing Market Segmentation
3. Global Market Analysis
3.1 Global Legionella Testing Market: An Analysis
3.1.1 Global Legionella Testing Market: An Overview
3.1.2 Global Legionella Testing Market by Value
3.1.3 Global Legionella Testing Market by Type (Culture Methods, Polymerase Chain Reaction Testing, Urinary Antigen Tests, Direct Fluorescent Antibody Tests, and Others)
3.1.4 Global Legionella Testing Market by Application (Water Testing, In-Vitro Diagnostics Testing, and Other Applications)
3.1.5 Global Legionella Testing Market by Region (North America, Europe, Asia Pacific, and rest of the world)
3.2 Global Legionella Testing Market: Type Analysis
3.2.1 Global Legionella Testing Market: Type Overview
3.2.2 Global Culture Methods Legionella Testing Market by Value
3.2.3 Global Polymerase Chain Reaction Legionella Testing Market by Value
3.2.4 Global Urinary Antigen Legionella Testing Market by Value
3.2.5 Global Direct Fluorescent Antibody Legionella Testing Market by Value
3.2.6 Global Others Legionella Testing Market by Value
3.3 Global Legionella Testing Market: Application Analysis
3.3.1 Global Legionella Testing Market: Application Overview
3.3.2 Global Legionella Water Testing Market by Value
3.3.3 Global Legionella In-vitro Diagnostics Testing Market by Value
3.3.4 Global Other Applications Legionella Testing Market by Value
4. Regional Market Analysis
4.1 North America Legionella Testing Market: An Analysis
4.1.1 North America Legionella Testing Market: An Overview
4.1.2 North America Legionella Testing Market by Value
4.1.3 North America Legionella Testing Market by Region (The US, Canada, and Mexico)
4.1.4 The US Legionella Testing Market by Value
4.1.5 Canada Legionella Testing Market by Value
4.1.6 Mexico Legionella Testing Market by Value
4.2 Europe Legionella Testing Market: An Analysis
4.2.1 Europe Legionella Testing Market: An Overview
4.2.2 Europe Legionella Testing Market by Value
4.2.3 Europe Legionella Testing Market by Region (Germany, France, UK, Spain, and rest of Europe)
4.2.4 Germany Legionella Testing Market by Value
4.2.5 UK Legionella Testing Market by Value
4.2.6 France Legionella Testing Market by Value
4.2.7 Spain Legionella Testing Market by Value
4.2.8 Rest of Europe Legionella Testing Market by Value
4.3 Asia Pacific Legionella Testing Market: An Analysis
4.3.1 Asia Pacific Legionella Testing Market: An Overview
4.3.2 Asia Pacific Legionella Testing Market by Value
4.3.3 Asia Pacific Legionella Testing Market by Region (China, Japan, India, and rest of Asia Pacific)
4.3.4 China Legionella Testing Market by Value
4.3.5 Japan Legionella Testing Market by Value
4.3.6 India Legionella Testing Market by Value
4.3.7 Rest of Asia Pacific Legionella Testing Market by Value
4.4 Rest of the World Legionella Testing Market: An Analysis
4.4.1 Rest of the World Legionella Testing Market: An Overview
4.4.2 Rest of the World Legionella Testing Market by Value
5. Impact of COVID-19
5.1 Impact of COVID-19 on Legionella Testing Market
5.2 Post COVID-19 Impact on Legionella Testing Market
6. Market Dynamics
6.1 Growth Drivers
6.1.1 Aging Population
6.1.2 Increasing Legionella Testing Demand From Hospitality Sector
6.1.3 Rising Incidence of Pneumonia and Legionella-related Illnesses
6.1.4 Increasing Focus of Government On Public Health
6.1.5 Aging Infrastructure
6.2 Challenges
6.2.1 Increased Difficulty in Legionella Detection
6.2.2 Limited Awareness about the Disease in Underdeveloped Countries
6.3 Market Trends
6.3.1 Increasing Adoption of Water Conservation Practices
6.3.2 Growing Focus on Adopting Preventive Measures
6.3.3 Ongoing Advancements in Diagnostic Technologies
6.3.4 Integration of IoT
6.3.5 Rising Demand For Rapid Diagnostic Tests
7. Competitive Landscape
7.1 Global Legionella Testing Market: Competitive Landscape
8. Company Profiles
8.1 F. Hoffmann-La Roche Ltd
8.1.1 Business Overview
8.1.2 Sales by Operating Business
8.1.3 Business Strategy
8.2 Abbott Laboratories
8.2.1 Business Overview
8.2.2 Operating Segments
8.2.3 Business Strategy
8.3 Merck KGaA
8.3.1 Business Overview
8.3.2 Operating Segments
8.3.3 Business Strategy
8.4 Bio-Rad Laboratories, Inc.
8.4.1 Business Overview
8.4.2 Operating Segments
8.4.3 Business Strategy
8.5 Becton, Dickinson and Company
8.5.1 Business Overview
8.5.2 Operating Segments
8.5.3 Business Strategy
8.6 QuidelOrtho Corporation
8.6.1 Business Overview
8.6.2 Operating Segments
8.6.3 Business Strategy
8.7 Thermo Fisher Scientific Inc.
8.7.1 Business Overview
8.7.2 Operating Segments
8.7.3 Business Strategy
8.8 IDEXX Laboratories, Inc.
8.8.1 Business Overview
8.8.2 Operating Segments
8.8.3 Business Strategy
8.9 Qiagen
8.9.1 Business Overview
8.9.2 Operating Regions
8.9.3 Business Strategy
8.10 Takara Bio Inc.
8.10.1 Business Overview
8.11 Eiken Chemical Co., Ltd.
8.11.1 Business Overview
8.12 AquaCert Ltd
8.12.1 Business Overview
8.13 Pro Lab Diagnostics Inc.
8.13.1 Business Overview
Figure 1: Benefits of Legionella Testing
Figure 2: Legionella Testing Market Segmentation
Figure 3: Global Legionella Testing Market by Value; 2019-2023 (US$ Million)
Figure 4: Global Legionella Testing Market by Value; 2024-2029 (US$ Million)
Figure 5: Global Legionella Testing Market by Type; 2023 (Percentage, %)
Figure 6: Global Legionella Testing Market by Application; 2023 (Percentage, %)
Figure 7: Global Legionella Testing Market by Region; 2023 (Percentage, %)
Figure 8: Global Culture Methods Legionella Testing Market by Value; 2019-2023 (US$ Million)
Figure 9: Global Culture Methods Legionella Testing Market by Value; 2024-2029 (US$ Million)
Figure 10: Global Polymerase Chain Reaction Legionella Testing Market by Value; 2019-2023 (US$ Million)
Figure 11: Global Polymerase Chain Reaction Legionella Testing Market by Value; 2024-2029 (US$ Million)
Figure 12: Global Urinary Antigen Legionella Testing Market by Value; 2019-2023 (US$ Million)
Figure 13: Global Urinary Antigen Legionella Testing Market by Value; 2024-2029 (US$ Million)
Figure 14: Global Direct Fluorescent Antibody Legionella Testing Market by Value; 2019-2023 (US$ Million)
Figure 15: Global Direct Fluorescent Antibody Legionella Testing Market by Value; 2024-2029 (US$ Million)
Figure 16: Global Others Legionella Testing Market by Value; 2019-2023 (US$ Million)
Figure 17: Global Others Legionella Testing Market by Value; 2024-2029 (US$ Million)
Figure 18: Global Legionella Water Testing Market by Value; 2019-2023 (US$ Million)
Figure 19: Global Legionella Water Testing Market by Value; 2024-2029 (US$ Million)
Figure 20: Global Legionella In-vitro Diagnostics Testing Market by Value; 2019-2023 (US$ Million)
Figure 21: Global Legionella In-vitro Diagnostics Testing Market by Value; 2024-2029 (US$ Million)
Figure 22: Global Other Applications Legionella Testing Market by Value; 2019-2023 (US$ Million)
Figure 23: Global Other Applications Legionella Testing Market by Value; 2024-2029 (US$ Million)
Figure 24: North America Legionella Testing Market by Value; 2019-2023 (US$ Million)
Figure 25: North America Legionella Testing Market by Value; 2024-2029 (US$ Million)
Figure 26: North America Legionella Testing Market by Region; 2023 (Percentage, %)
Figure 27: The US Legionella Testing Market by Value; 2019-2023 (US$ Million)
Figure 28: The US Legionella Testing Market by Value; 2024-2029 (US$ Million)
Figure 29: Canada Legionella Testing Market by Value; 2019-2023 (US$ Million)
Figure 30: Canada Legionella Testing Market by Value; 2024-2029 (US$ Million)
Figure 31: Mexico Legionella Testing Market by Value; 2019-2023 (US$ Million)
Figure 32: Mexico Legionella Testing Market by Value; 2024-2029 (US$ Million)
Figure 33: Europe Legionella Testing Market by Value; 2019-2023 (US$ Million)
Figure 34: Europe Legionella Testing Market by Value; 2024-2029 (US$ Million)
Figure 35: Europe Legionella Testing Market by Region; 2023 (Percentage, %)
Figure 36: Germany Legionella Testing Market by Value; 2019-2023 (US$ Million)
Figure 37: Germany Legionella Testing Market by Value; 2024-2029 (US$ Million)
Figure 38: UK Legionella Testing Market by Value; 2019-2023 (US$ Million)
Figure 39: UK Legionella Testing Market by Value; 2024-2029 (US$ Million)
Figure 40: France Legionella Testing Market by Value; 2019-2023 (US$ Million)
Figure 41: France Legionella Testing Market by Value; 2024-2029 (US$ Million)
Figure 42: Spain Legionella Testing Market by Value; 2019-2023 (US$ Million)
Figure 43: Spain Legionella Testing Market by Value; 2024-2029 (US$ Million)
Figure 44: Rest of Europe Legionella Testing Market by Value; 2019-2023 (US$ Million)
Figure 45: Rest of Europe Legionella Testing Market by Value; 2024-2029 (US$ Million)
Figure 46: Asia Pacific Legionella Testing Market by Value; 2019-2023 (US$ Million)
Figure 47: Asia Pacific Legionella Testing Market by Value; 2024-2029 (US$ Million)
Figure 48: Asia Pacific Legionella Testing Market by Region; 2023 (Percentage, %)
Figure 49: China Legionella Testing Market by Value; 2019-2023 (US$ Million)
Figure 50: China Legionella Testing Market by Value; 2024-2029 (US$ Million)
Figure 51: Japan Legionella Testing Market by Value; 2019-2023 (US$ Million)
Figure 52: Japan Legionella Testing Market by Value; 2024-2029 (US$ Million)
Figure 53: India Legionella Testing Market by Value; 2019-2023 (US$ Million)
Figure 54: India Legionella Testing Market by Value; 2024-2029 (US$ Million)
Figure 55: Rest of Asia Pacific Legionella Testing Market by Value; 2019-2023 (US$ Million)
Figure 56: Rest of Asia Pacific Legionella Testing Market by Value; 2024-2029 (US$ Million)
Figure 57: Rest of the World Legionella Testing Market by Value; 2019-2023 (US$ Million)
Figure 58: Rest of the World Legionella Testing Market by Value; 2024-2029 (US$ Million)
Figure 59: Global Total Population Aging 65 and above; 2018-2022 (Million)
Figure 60: Global Travel and Tourism Market Revenue; 2019-2025 (US$ Billion)
Figure 61: F. Hoffmann-La Roche Ltd Sales by Operating Business; 2023 (Percentage, %)
Figure 62: Abbott Laboratories Revenue by Segment; 2023 (Percentage, %)
Figure 63: Merck KGaA Net Sales by Segment; 2023 (Percentage, %)
Figure 64: Bio-Rad Laboratories, Inc. Net Sales by Segments; 2023 (Percentage, %)
Figure 65: Becton, Dickinson and Company Revenue by Segment; 2023 (Percentage, %)
Figure 66: QuidelOrtho Corporation Revenue by Operating Segment; 2022 (Percentage, %)
Figure 67: Thermo Fisher Scientific Inc. Revenue by Segment; 2023 (Percentage, %)
Figure 68: IDEXX Laboratories, Inc. Revenue by Operating Segment; 2023 (Percentage, %)
Figure 69: Qiagen Net Sales by Regions; 2023 (Percentage, %)